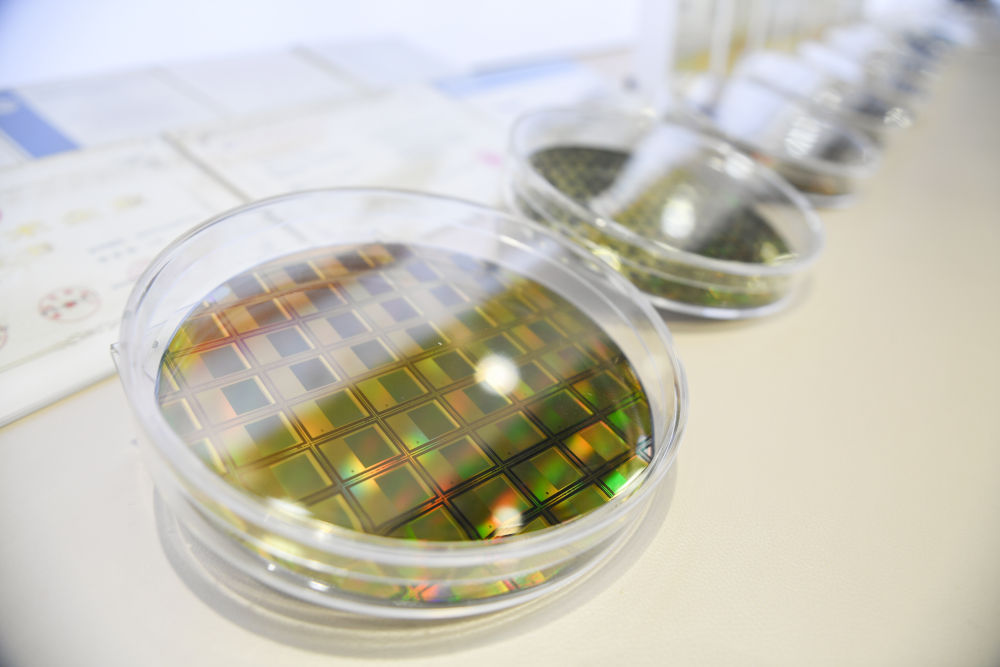

這是2月28日拍攝的武漢高德紅外股份有限公司(無人機照片)。新華社記者 杜子璇 攝
能見度不到100米的濃霧天氣里,一架無人機騰空而起。通過機上紅外探測系統,公安交管部門能清晰“看到”高架橋上緩行的車流,并有針對性地作出決策。
在物理學中,凡是高于絕對零度的物質,都會依據溫度的不同對外輻射電磁波。利用這一特性,紅外探測技術成為突破人類視覺障礙探測物體的利器。高靈敏度、高可靠性、高分辨率的紅外探測核心器件更是各國角逐的焦點。
20多年來,武漢高德紅外股份有限公司(以下簡稱“高德紅外”)從零起步、不等不靠、勇往直前,成功研制出擁有完全自主知識產權的紅外探測器芯片,有效打破國外壟斷,解決國內重大需求。

十年磨一“芯”
位于武漢的中國光谷,新春開工正忙。高德紅外終端生產線上,身穿靜電服的工作人員正在調試一款觀瞄型熱成像夜視儀。透過生產線測試屏幕,只見影像正隨溫度變化,呈現出不同亮度和色塊。

2月28日,在高德紅外智感科技民品生產線上,工作人員對紅外熱成像儀進行程序燒錄。新華社記者 杜子璇 攝
“你看,臉部整體高亮,但戴眼鏡的地方就偏黑,這是因為散發的能量溫度不同?!备叩录t外董事長黃立介紹,紅外探測器芯片可以把肉眼不可見的紅外線,轉化為光電信號和成像,幫助人們更好洞悉身邊環境?!斑@款夜視儀很受戶外愛好者青睞,很快將出口海外?!?/p>

黃立(右三)與科研人員在高德紅外生產調試車間忙碌(2020年2月11日攝)。新華社發
作為紅外行業領軍企業,高德紅外年產各類紅外產品150多萬臺,銷往全球70多個國家和地區。在民用熱成像市場的占有率居中國第一、全球第二。這些放在十多年前,簡直是難以想象。
高德紅外成立之初主要用進口芯片組裝工業用紅外測溫儀。由于國外出口管制,長期以來,中國企業只能進口最低端的芯片,且數量少、價格高、交貨周期長?!百u給你的芯片連售后都沒有,你愛要不要?!秉S立說,即便這樣,2008年高德紅外還是遭遇進口芯片斷供。
“芯片就是‘心臟’,沒有它,企業的命運就掌握在別人手里,隨時可能死亡?!秉S立逐漸意識到,關鍵核心技術是要不來、買不來、討不來的。于是,高德紅外開啟了漫漫“追芯”路。
“從零起步,任何一個技術難點都會讓你‘卡殼’?!?009年入職高德紅外的中國科學院上海技術物理研究所博士周文洪說,氧化釩是制造紅外芯片的基本原料,它的配比及加工時的溫度、氣壓等直接關系芯片性能。沒有技術參考,科研人員只能“硬剛”,“耗時2年多、1000多次試驗,相關問題才得以攻克?!?/p>
缺技術,就翻遍資料文獻尋找蛛絲馬跡;缺設備,就借用外地專業院所機器開展樣品研發;缺材料,就托人東挪西借,有一點用一點;缺資金,就提高研發經費投入強度,將上市募資全部用于研發……
歷經9年多時間、投資近20億元、突破數百項技術難題和數千項工藝難關,高德紅外自主研發的高性能制冷單色百萬像素紅外探測器芯片于2017年成功面世,2018年實現量產。這一國產紅外芯片的問世,直接將同類型進口產品價格拉低50%以上。

攀登無止境
走進高德紅外產品展廳,幾十款大大小小、形狀各異的紅外探測器映入眼簾。它們有的只有指甲蓋大小,卻集成了傳感器等重要設備;有的被厚重金屬外殼包裹,可適應零下200攝氏度的極端工作環境;有的可裝載在其他設備上,能夠高靈敏度、全天候、全被動工作……
這是2月28日在武漢高德紅外股份有限公司產品展廳內拍攝的展品。新華社記者 杜子璇 攝
一款款紅外探測器,展示了高德紅外的技術實力,更彰顯著企業堅定自主創新、把科技命脈牢牢掌握在自己手中的決心。

這是2月28日在武漢高德紅外股份有限公司產品展廳內拍攝的展品。新華社記者 杜子璇 攝
黃立介紹,高德紅外在生產出單色百萬像素紅外探測器芯片時,少數國家已掌握雙色百萬像素紅外探測器芯片技術,我國在此方面與之差距明顯。
紅外芯片要實現從“單色”到“雙色”突破,并非易事。高德紅外芯片研發負責人劉斌介紹,紅外芯片要通過讀出電路,將光轉化成電子后,采集放大并以視頻格式輸出。這需要電路與芯片互聯互通。一個雙色芯片有130多萬個像素,每個像素都有一個焊點,要在蠶豆大小的芯片上制備如此密集的焊點并確?;ヂ摶ネó惓@щy。
劉斌說,焊接雙色紅外芯片的倒裝焊接機精度要求在1微米以下,而當時國內只有3微米左右倒裝焊接機,且無法進口高精度設備。高德紅外研發人員只好不停地試驗、總結、修改方案。最終,一舉攻克了讓130多萬個像素點連通率達99.99%以上的微組裝技術難題。
從單色百萬像素芯片到雙色百萬像素芯片,高德紅外瞄準國際領先技術的腳步從未停歇。目前,該企業已搭建起非制冷探測器、制冷型碲鎘汞及二類超晶格3條完全自主可控的批量生產線,具備多種型號探測器芯片的研制生產能力。公司核心器件技術水平已與西方國家第一梯隊持平,并成功實現核心器件全面國產化。

融合再跨越
2月22日15時02分,武漢東湖新技術開發區,一架無人機在空中巡查發現,雄楚大道高架往關山大道方向的匝道有車輛因道路結冰陷車,導致擁堵。公安交管部門隨即派出警力鏟冰除雪,15時20分,道路恢復暢通。
“這架無人機之所以如此精準,因為它有雙‘高清紅外眼睛’?!蔽錆h市公安局東湖新技術開發區分局相關負責人介紹,借助實時回傳的高清紅外畫面,指揮中心能夠全天候掌握道路結冰、交通擁堵等路況信息,進行科學決策。
正是因為中國自主紅外芯片的突破,紅外熱成像技術才大范圍普及。目前高德紅外部分型號的紅外芯片成本已降到幾百元,隨著紅外核心芯片小型化、低成本、高可靠性、大批量生產的實現,紅外科技產品迎來飛入尋常百姓家的契機,也為千行百業的迭代更新帶來更大的想象空間。
自動駕駛集成紅外模塊,可穿透黑暗、雨霧精準發現行人,保證駕駛安全;智能空調集成紅外模塊,可根據人員數量、方位、姿態調節風向風速,既節能又精準;電力線路檢測整合紅外模塊,可更快發現溫度異常和隱患,提高檢測精度和效率……高德紅外的探測器已被廣泛應用于人體測溫、工業測溫、安防監控、消防救援、戶外運動、自動駕駛等領域。

2月28日,在高德紅外智感科技民品生產線上,工作人員在操作設備對紅外模組進行數據采集。新華社記者 杜子璇 攝
當前,高德紅外正全面打造紅外“芯”平臺戰略,圍繞產業鏈部署創新鏈,圍繞創新鏈布局產業鏈。通過不同行業、企業間優勢互補、資源共享,推動紅外技術的規?;?、多樣化、普及化和消費化,共同打造紅外生態圈。
“有人跟我說,紅外芯片研發是國家的事,民企沒必要折騰,但事實證明,掌握核心技術,實現自立自強,每個人都義不容辭?!秉S立說,正是由于堅持不懈地推進自主創新,高德紅外才取得了今天的成績。
“沒有做不到的,只有想不到的?!痹诟叩录t外園區中心花園里,鐫刻著這樣一句話,往來員工會不由自主地抬頭看看?!懊恳淮硕加凶约旱臋C遇,我們不能辜負這個偉大的時代?!辈簧賳T工如是說。

文字記者:李鵬翔、徐海波、王自宸
視頻記者:余國慶、饒饒、潘志偉
編輯:儲興華、王化娟、鄭雅寧、張浩波、徐金泉、侯幫興、郭潔宇
統籌:黃小希、何雨欣


